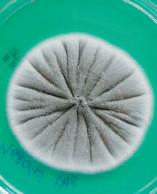

ISBN 978-966-97695-3-4













які відповідно до принци-
пу комплементарності здатні копіюватися (реплікуватися) з
точністю. Зрештою усе живе з часом змінюється, збільшуючи свою пристосованість (адаптуючись) до умов навколишнього середовища. Це відбувається завдяки процесу еволюції. Саме еволюція є тією ознакою живого, що веде до збільшення біо-
логічного різноманіття і породжує
нові унікальні особливості життя. Наостанок варто зазначити, що лише одна чи кілька ознак живо-
не є достатніми для віднесення
об’єкта до живої чи неживої при-
роди. Так, наприклад, вода з льодовиків «живить» гірські озера й, випаровуючись, «виділяється» з них, кристали солі




стверджувати, що
жуть вважатися живими. Функціонування


об’єкти вивчення фізики, хімії, географії і
біології різняться, усім зро-
зуміло, що знання однієї науки потрібні в іншій. Так, н априклад, для вивчення процесів передачі нервових імпульсів біологам треба ро




корму для тварин. Згідно з правилом
моря та негативних наслідків не лише для
природи, а й для населення усього регіону.


■
1
2
3









(Plantae)
(Angiospermae)
(Platyhelminthes)
(Triuridaceae)
(Lacandonia)
(Diplozoidae)
Lessard,


Scaptia beyonceae
Lessard, 2011
Legionella shakespearei Verma et. al., 1992.
Nazari,
Otocinclus batmani Lehmann
A., 2006,
— Darthvaderum greensladeae Hunt, 1996
■
■
■
ною мембраною, що складається з ліпідів і білків. Ліпіди формують структурну основу мембрани, а білки на-
їй унікальних властивостей та беруть участь











В
мають уні-
кальну плазматичну мембрану, ліпіди якої є етерами,
а не естерами, як у інших організмів (рис. 5.7, В). Понад те, часто мембрана
представлена лише моношаром ліпідів,
які мають дві по -
лярні голівки і не -
полярну частину посередині — подібної організації немає в жодних інших
організмів. Клітинна стінка, якщо
в она є, побудована
не з муреїну,



1.
2.
3.
4.








завдяки диханню, тільки цього разу — безкисневому. Як окисник замість кисню вони використовують нітрат, відновлюючи його до молекулярного азоту. Останній вивільняється в атмосферу, що призво-
дить до зниження родючості ґрунту.

використовувати

й запобігають
розвиткові патогенної мікрофлори. Біфідобактерії
витісняють потенційно хвороботворних бактерій
із кишківника, формуючи потужний бар’єр на
шляху інфекцій. З часом, після відмови від молочного харчування, біфідобактерії поступаються своїм панівним становищем кишковій паличці. Проте біфідобактерії










1.
3.
низки біохімічних
процесів,




ядрами. Наявність статевого процесу підтримує генетичне різнома-
ніття в популяціях інфузорій.
Незвичайна група одноклітинних організмів супергрупи SAR, що ведуть виключно паразитичний спосіб
життя




мембран. Зелені водорості багато в
чому схожі на рос-
лини, утім більшість
зелених водоростей одноклітинні (рис. 7.8). Хоча існують і багатоклітин-
ні зелені водорості
(див. рис. 2.3, А).
Типовим представ-
ником зелених водоростей є хламідомо-
нада — прісноводна одноклітинна









Д
■ 2. Виберіть
А ціанобактерія → червона
В ціанобактерія → зелена водорість
Г альфа-протеобактерія
1. SAR
2. Архепластида
3. Екскавата
4. Амебозоа















Б 1 —
2 — гамет, 3 — судинних рослин В 1 — гаплоїдний, 2 — спор, 3 —
Г 1 — диплоїдний, 2 — гамет, 3 — мохоподібних
Д 1 — гаплоїдний, 2 — гамет, 3 — мохоподібних ■ 2. Стебло
■
1.
2.
3.
■
■
■

водоростевий фікобіонт. Мікобіонтами, переважно, є сумчасті гриби, тоді як фікобіонтом, зазвичай, виступає зе-
лена водорість, іноді — ціанобактерія. У лишайнику клітини водоростей розташовуються між нитками
ними навіть формуються







4.
■













одельні організми — це ті істоти, яких зручно використовувати для досліджен-
певних процесів і явищ живого
Саме вони є «лідерами» ви-
над ними проводять бага-
експериментів, вони є найкраще
для них розроблено
дослідницькі процеду-
Зазвичай модельними стають
тварин, яка викорис



















1.
2.
3.
4.
при цьому всі організми ха-
спільними властивостями. По-перше, усі вони мають клітинну будову.



роках, тоді як штам гри-
А H3N2 був причиною пандемії
в 1968–1969 роках, що забрала життя 34 тис.
































компонен-

3.
■ 7.
■

важливіші типи
це лише най-
серед біль-
ніж 30 її типів. РНК формує різнорівневі структури, що робить її
поліфункціональною
Оскільки РНК складається з
одного ланцюга, вона може утворювати складніші просторові структури. РНК формує вторин-
ні структури: шпильки та петлі (рис. 16.3, А). Зокрема, РНК ри-
босом і транспортна РНК формують такі структури (рис. 16.3, Б).






CRISPR/Cas9 система була від-
в спрямо-
РНК. Остання приєднується
ферменту Cas9, що може робити
Cas9,
зі спрямовуючою
тині: як ті, що належать бактерії, так і ті, що походять
якщо в них є комплемен-
(наприклад,
Г 1 — ДНК, 2 — РНК, некомплементарні
■ 2. Для того, щоб молекула
А урацил, дезоксирибозу
3.
4.



1. полегшення протікання реакції
2. заглибина в молекулі ферменту, що
3. пригнічення протікання реакції
4. енергія, яку потрібно
■
■
■
Кофактори — елементарні «інструменти»
ферментів
Тепер,
ми 1. Кофактори — це небілкові компоненти
їх самостійно.
В1 (тіамін) виконує роль









клітини окремих білків та
мітохондрій і хлоропластів
■



отримані ззовні (вугле -
кислий газ, вода). Отже фотоавтотрофи
як і фотоавтотрофи, використо -
енергію
використовувати органічні речовини як джерело
проте можуть
їм сполук.




1. бактерія K потребує кисню,
2. бактерія
1.
2.
3.
4.
■
відмінні риси обміну вуглеводів, лі-
та білків, взаємозв’язок цих обмі-
Зробіть
Травлення,
утворення ацетил-КоА,
Кребса,
глюконеогенез
травлення,
транспортування кров’ю, утворення
жири поліненасиченими (рідкими). Це запобігатиме накопиченню в організмі хо -
лестеролу й насичених жирних кислот, що можуть спри-
порушення в роботі серцево-судинної
випадках можуть закінчуватися летально. За даними ВООЗ,

3.
4.
■
1. уникайте вживання солодощів, чіпсів і газованих напоїв
2. мийте руки та продукти перед
3.
4.
генетичних порушень
попередньому параграфі ми обговорили, що таке
харчування і як його реалізувати. Цей
присвячений хворобам метаболізму — захворюванням,
виникають внаслідок нездорового харчування
через генетичні порушення. Наразі відомо багато таких хвороб, але ми ознайомимося із









Рис. 24.6.
Рис. 24.7.
1.
2.
3.
4.
визначає його функцію. Відповідно особливості функ-
організму.
— генотипу — з умовами
довкілля, а також випадкових факторів.
Так, у людини може
бути генетична схильність до повноти, але те, яку фігуру вона
буде мати, певною мі-
рою залежатиме від умов довкілля й спосо-
бу життя: дієти й рів-
ня фізичних навантажень. Прикладом
випадкових факторів, що визначають роз-
виток ознаки, може слугувати формуван-
ня папілярних ліній
на подушечках пальців. Хоча формування
■
■

1. промотор
2. термінатор
3. старт-кодон
4. стоп-кодон
тобто така, яку

зиготи. Оскільки
сперматозоїди й спермії зазвичай
1. екзон
РНК-полімераза — фермент, що забезпечує
і у ви-
падку з ДНК-полімеразою, РНК-полімераза

Рис. 28.5.
код еволюціонував. Зараз є всі підстави вважати, що
плетним, тобто амінокислоти кодувалися двійками
нуклеотидів (амінокислот було, таким чином, не
2.Антикодон
3.Рибосома
■
не менше 500 генів,


Папороть
(1440)

Мунтжак індійський (6)


(2)

китайський (46)
(176)

розумна (46)



1.
2.
3.
4.
■
■
ділянками між материнською та
батьківською хромосомами. При
цьому хромосоми, що виникають, виявляються ніби зшитими з фрагментів батьківських і мате -
ринських хромосом, як клаптева ковдра. Такий процес називають
кросинговером (рис. 31.2). Разом із проходженням кро-
хромосом

від покоління до покоління. Виявляється, що
закономірності спадковості є прямим наслідком механізмів мейозу й запліднення. Найпростішим
варіантом є успадкування при
моногібридному схрещуванні (запиленні рослин чи спаровуванні тварин). Моногібридне схрещуван-
1.
2.
3.
4.
1 : 1
3 : 1




дальтонізм синові. Прояв деяких
ознак обмежено стат-
1.
4.
Очевидно, що всі діти матимуть генотип
AaBb, тобто будуть гетерозиготами за обома
генами, які розглядаються. Такі організми
називають дигетерозиготами. За фенотипом
усі вони будуть кароокими й темноволосими.
Припустимо, що в
дигетерозиготних бать-



AABb
AaBB
AAbb
AaBb
AaBb
Aabb
Aabb

генів? Позначимо природні
функціональні алелі як H
і O, а мутантні нефункціо-
нальні — як h і o (табл. 33.5). Очевидно, що така мо-
дель може пояснити народження кароокої дитини
в пари блакитнооких бать-
ків (рис. 33.3). Якщо мати несе функціональний алель
Неспадкова
навколишнього
розвитку. Відмінності, що виникають
як температура, режим
світла, можуть
розвивається лялечка, забарвлення крил
метелика може дуже варіюватися. Ще
один цікавий приклад модифікаційної
мінливості — забарв-
лення квітів гортензії (рис. 34.1, Б). Якщо
вирощувати її на кислому ґрунті, то квітки
мають блакитне
лужному — рожеве. Колір пелюсток визначається наявністю синього пігменту






Рис. 34.3.
1.
2.
3.
1.
■
хро-

гамет лише тому, що відбулося неза-
лежне розходження хромосом. У людини
23 хромосоми в гаплоїдному наборі, отже, кількість можливих


Рис. 35.6.
■
■

призводить до порушення
синтезу зорових пігментів, що
дальтонізмом зустрічаються
дальтонізмом.



лікуванням. Він є виправданим, адже для того, щоб усунути причину
захворювання, необхідно змінити генетичну інформа-
цію у величезній кількості клітин усього
модифікацію «у пробірці», після чого повернути
клітини до тіла людини.
Так, у 2017 році в Бохумі (Німеччина) вперше
вилікували бульозний
епідермоліз — важке ге-
нетичне захворювання, що полягає в порушенні цілісності епідермісу шкіри: будь-який дотик
викликає формування ран і пухирів, люди з цим захворюванням відчувають постійний біль.
Спершу лікарі виділили стовбурові клітини зі
шкіри хлопчика, після
чого модифікували їх за
допомогою використання вірусів. Потім із цих
було отримано
шкіри, що й було

3.
■
■ 8.
■
■
Медико-генетичне








юдський вид поділений на
кілька рас, а ті, у свою чергу, на дрібніші популяції. У
складі кожної раси наявні популяції, усередині яких шлюби ймовір-
ніші, ніж між різними популяція-
ми. Ця ізоляція підтримується не стільки фізіологічними причинами, скільки культурними й територі-
альними: різне місце проживання, мова, релігія роблять шлюби менш
Якісь народи величезні
народ хань, представ-
якого приблизно 1,3 млрд осіб),
1.




розмноження доволі поширене у світі рослин. Близький родич товстянки — бріофіллум (відомий також як
каланхое) (рис. 39.1, Б) —
нюються, перетворюючись
на самостійні рослини.
Вегетативне розмноження
трапляється
по -
у живій природі.
Серед тварин він трапляється у скельних ящірок,
сріблястого карася, дафній
(рис. 39.4, А, Б, В). Популяції організмів, що розмно-
жуються партеногенетично, часто складаються з одних
лише самиць. Але в деяких
видів у популяції періодично
з’являються самці, які беруть
участь у роздільностатевому
розмноженні, забезпечуючи
обмін генами.
Цікава форма парте-
перетинчастокрилих комах:






4.
■

1.
2.
3.
4.



симбіотичних мікроорганізмів.
Згадане середовище є
згубним для сперматозоїдів, тому більша їхня частина гине в піхві.
Однак найстійкіші й
найспритніші проникають до матки. Далі крізь матку вони потрапляють у фаллопієві (маткові) труби. Саме тут сперма-

1.
2.
3.
■
■
■

2
шару клітин —
ектодерми 2 , формуватиметься епідерміс шкіри, а також нервова система й органи чуття.
Середній шар клітин —
мезодерма 3 — дасть початок опорно-руховій, кровоносній і видільній системам, статевим залозам й іншим структурам. Із внутрішнього

скелет, кровоносна й нервова системи. Цікаво, що
для ембріона характерна
низка ознак, наявних у давніх предків людини.
Найяскравіше виражени-
серед них є зяброві дуги
й хвіст (рис.42.5), а також хрящовий скелет. Отже,

розмір

ся кістковою. За
допомогою якісної
ультразвукової діа-
гностики плода в

Рис. 42.9.

ептилії, птахи й ссавці відріз-
від інших хребетних
особливих ембріональних структур — позазародко-
оболонок. Це вирости стінки тіла ембріона, які його повністю оточують
1. дроблення
2. гаструляція
3.

доведено, що люди, які живуть у сільській
■ 6.
ки — ендометрію. Якщо
після овуляції відбудеться запліднення, то ембріон вросте в ендометрій і розпочнеться розвиток зародка. Якщо запліднення
не відбудеться, то ендометрій буде виведено з організму під час маткової кровотечі — менструації й
починається новий цикл (рис. 44.1). У ссавців із сезонним паруванням піс-
ля одного чи кількох по-
дібних циклів 1 розвиток яйцеклітин зупиняється
до наступного сезону парування. У
протягом
ці. Ніколи не використовуйте презервативи
вдруге, після завершення терміну придатності чи в пошкодже-
ному пакуванні, через значне зниження їх-

ньої ефективності й можливу наявність пошкоджень. Головними перевагами чоловічих презервативів є легкість у використанні, доступність, висока ефективність

при проблемах із
при порушеннях прохідності
маткових труб, використовують
екстракорпоральне 2 або штучне
запліднення (рис. 44.3, А). Для цього в жінки стимулюють су-
перовуляцію: дозрівання одразу
кількох яйцеклітин. Ці яйцеклітини виділяють з організму
й запліднюють спермою батька
в лабораторних умовах («у про-
бірці»). Якщо сперматозоїди ма-
лорухливі чи їх мало в спермі, то здійснюють інтрацитоплазма-
тичну ін’єкцію сперматозоїда в яйцеклітину (рис. 44.3, Б). Ембріони кілька днів підрощують
на спеціальному середовищі за
постійної температури і, протестувавши зародок на відсутність
вад і генетичних хвороб, пересаджують до матки. Як правило, через меншу за 100 % ефектив-

1. чоловічий
зерватив
2. гормональні
4.



На сьогодні розробляють нові, експериментальні способи лікування раку, більш специфічні стосовно ракових клітин, тому
не мають таких побічних ефектів, як хіміо- і радіотерапія. Наприклад, колоїдне золото
може використовуватися для лікування багатьох форм раку.
До організму

Д інтерфаза стане більш тривалою
■ 2. Під час інтерфази
1. G1-фаза
2. G2-фаза
3. S-фаза
4. G 0 -фаза




Саме з них
формуються всі ор-
гани й тканини людського
Вирощуючи їх поза
організмом, учені мо-
жуть отримати деякі
органи й тканини, щоб потім викорис-
тати для пересадки в організм людини (рис. 46.3).
Альтернативою
ембріональним стов-
продаж нирок заради великого заробітку. По-
дібна тенденція наразі
спостерігається в еконо -
мічно бідних країнах.
Однак після видалення
нирки здоров’я люди-
ни



1. уніпотентна стовбурова клітина
2.
■ 3.
■ 4.













Alberts A., Johnson J., Lewis M., Raff K., Roberts K., Walter P.Molecular biology of the cell, — 5th ed. — J. Wiley & Sons, 2008.
Flint J., Racaniello V. R., Rall G. F., Skalka A. M., Enquist L. W. Principles of virology, — 4th edition. — ASM Press, 2015.
Hickman С. P., Jr., Roberts L. S., Larson A. Integrated principles of zoology, — 11th ed. — McGraw-Hill Higher Education. — 2001.
Mader S. S., Windelspecht М. Essentials of biology, — 5th ed. — McGraw-Hill Education, 2018.
Mader S. S., Windelspecht М. Human biology. — 15th ed. — McGraw-Hill Education, 2018.
Nelson D., Cox M. Lehninger Principles of Biochemistry, — 6th ed. — W. H. Freeman, 2012.
Pierce B. Genetics. A conceptual approach, — 5th ed. — W. H. Freeman, 2013.
Urry L., Cain M., Wasserman S., Minorsky P., Reece J. Campbell Biology, — 11th ed. — Pearson Higher Education, 2016.
www.rcsb.org/
www.ncbi.nlm.nih.gov/gene
www.ensemblgenomes.org/
www.compoundchem.com/
EdEra www.courses.edera.com/courses/coursev1:EdEraOsvitoria+BIO+1/about
А
Адипоцит 146
Адреналін 147
Азотфіксація 37
Алель 169, 171–172, 207
Амеби 49, 261
Амінокислоти 114, 143
Андрогенез
див. також Партеногенез 264
Андрогени 283
Антибіотики 31–33, 62
Антиоксиданти 164–165, 285
Апарат
43, 268
Апікомплекси 45–47
Апоптоз 295–296
Ареал 253
Археї 33, 36, 38
АТФ 43, 130–131
АТФ-синтаза 114, 132–133
Б
Бактерії 30–32, 39, 98, 155
— геном 179–180
— значення у природі 38–40, 99–100
— роль у виникненні еукаріотів
Теорія ендосимбіотична
хвороби 39–40, 154, 196 Бактеріофаг 84, 90, 99
114–115, 150
292
175–176, 182
121, 146, 157
194–195
Подразливість 7
Полісахариди 105
Популяція 10, 252–253
Постембріогенез 275, 282–283
Принцип комплементарності 112, 169–170
Природній добір 98 Пріон 93–95 Прокаріоти див. також Археї, Бактерії 29
Пухлини
— доброякісні 296
— злоякісні 92, 164, 296–297
Р
Радіотерапія 298
296–298 Рахіт 128 Регенерація 69, 300
Реплікація 170, 186
Рибозими 93, 113
Рибосома 43, 174, 194–196
РНК 112–113
РНК-полімераза 112, 174, 185–186 Розмноження 7, 261
— вегетативне 261–262
— нестатеве 261, 264
261–263, 270
Сперматогенез
310
§
§